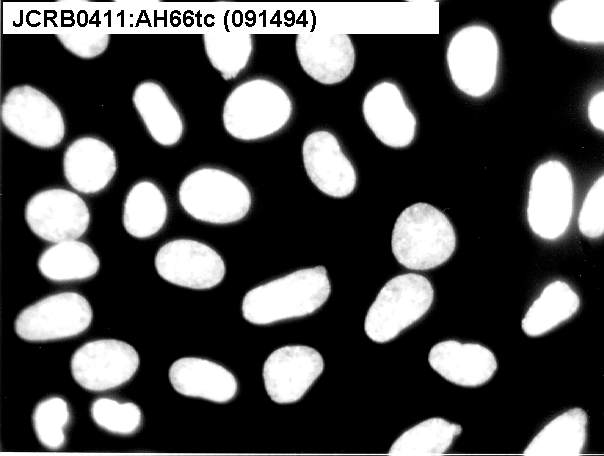

JCRB0411 AH66tc
Cell information
Cell type:general cells (View Pricing Information)
| JCRB No. | JCRB0411 | Cell Name | AH66tc |
|---|---|---|---|
| Profile | ascites hepatoma, (Donryu rat) | Other Name | AH66tc |
| Animal | rat | Strain | Donryu |
| Genus | Rattus | Species | norvegicus |
| Sex | Age | ||
| Identity | Tissue for Primary Cancer | liver | |
| Case history | Metastasis | ||
| Tissue Metastasized | Genetics | Yoshida ascites hepatoma | |
| Life Span | Crisis PDL | ||
| Morphology | Character | Yoshida ascites hepatoma | |
| Classify | Established by | Tabuchi,K. & Sato,J. | |
| Registered by | Sato,J. | Regulation for Distribution | |
| Comment | High production of alpha-fetoprotein. | Year | 1985 |
| Medium | Eagle's minimal essential medium with 10% fetal bovine serum. | Methods for Passages | Cells are treated with 0.2% trypsin and 0.02% EDTA . |
| Cell Number on Passage | few cells OK | Race | |
| CO2 Conc. | 5 % | Tissue Sampling | liver |
| Tissue Type |
| Detection of virus genome fragment by Real-time PCR | |||||||||
|---|---|---|---|---|---|---|---|---|---|
| Detected DNA Virus | not tested | Detected RNA Virus | not tested | ||||||
| Reference | |
|---|---|
| Pubmed id:4358144 | Toxic metabolites released from rat hepatoma cells in culture. I. Effects of metabolites of hepatomas on various cells. Katsuta H,Takaoka T,Yasumoto S J Natl Cancer Inst. 1973 Dec;51(6):1841-4 |
| Images |
|---|
![]() ![]() ![]() |
| Movies |
|---|
|
|